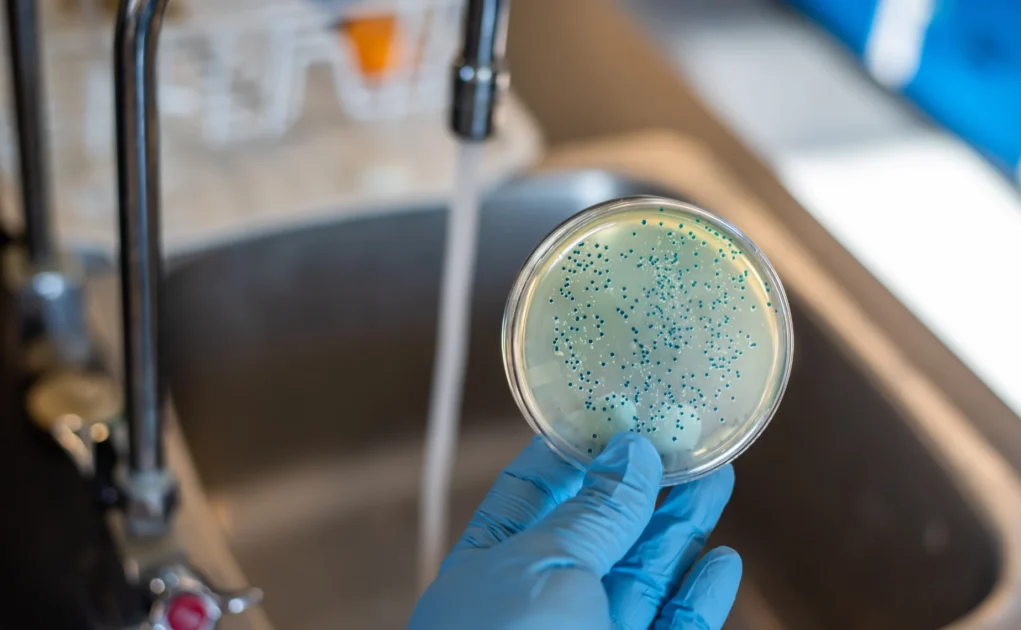
Water Contamination in Lalitpur

There is seen to be all tap water in Lalitpur’s Ward 3 with harmful bacteria called faecal coliform. People are saying that the water is contaminated with sewage which may contain a serious health risk. It will be dangerous when these types of issues occur especially when waterborne diseases like cholera spread in the rainy season. Authorities are trying to improve this issue and give proper concern to the water system
Water Contamination in Lalitpur Sparks Health Risks